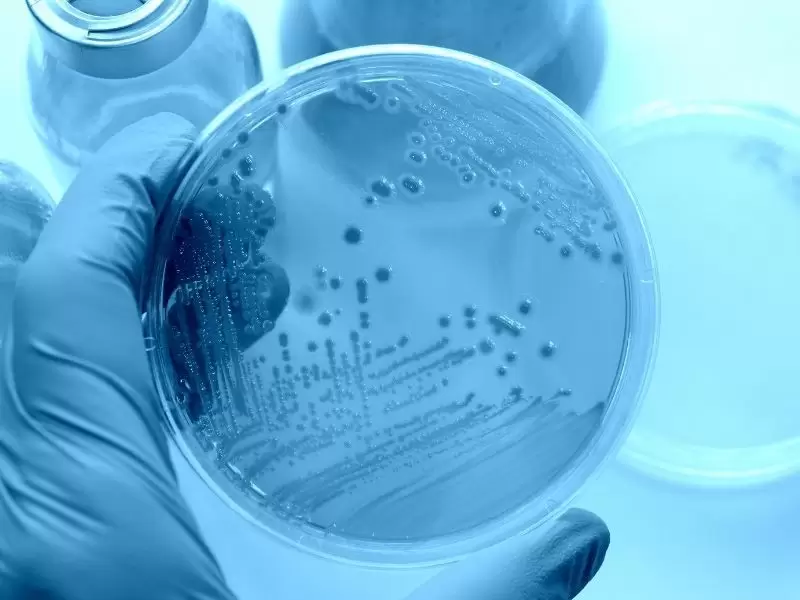

Tıbbi Birimler
EKG, Efor Testi, Ekokardiyografi, Stres Ekokardiyografi, Ritm Holter Monitörizasyon, …
Devamını OkuKalbi besleyen koroner atardamarlarında meydana gelen tıkanıkların cerrahi tedavisidi…
Devamını OkuDahiliye Polikliniğimizde; Şeker (Diyabetes Mellitus) Kontrolü ve Takibi, HBA1C …
Devamını OkuHastanemizde gerek yatan gerekse ayaktan müracaat eden hastaların röntgen, ultr…
Devamını Okuİlgili tüm testleriniz yapılmaktadır.…
Devamını Okuİlgili tüm testleriniz yapılmaktadır.…
Devamını OkuAcil servisimiz kaliteli sağlık hizmeti sunumunun sağlanması için 7 gün 24 saat kesin…
Devamını Oku